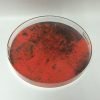

Custom Acrylic Trays Manufacturer & Supplier
Enhance both functionality and aesthetics with our custom acrylic trays, designed for organization, display, and presentation across home, retail, and commercial environments. From vanity organizers and serving trays to product display and merchandising solutions, our acrylic trays combine crystal-clear transparency, modern design, and durable construction to meet professional use requirements.
As a professional acrylic tray manufacturer, AP Acrylic specializes in the production of custom acrylic trays and organizers in a wide range of sizes, thicknesses, colors, and structures. All trays are manufactured using premium acrylic materials and finished with smooth, polished edges for a clean, safe, and long-lasting result—ideal for both consumer-facing and brand-driven applications.
Custom acrylic serving tray One-Stop solutions
As a leading custom acrylic tray supplier, AP Acrylic server clients in 30+ countries worldwide and we support retailers, distributors, brand owners, and interior designers with wholesale acrylic tray solutions and private-label manufacturing. Whether you need bulk acrylic trays for resale or fully customized OEM/ODM designs with logo, we provide end-to-end services—from design consultation and sampling to mass production and global delivery.
Clear acrylic tray with hole handle
White acrylic tray with artwork printing
Custom folding clear acrylic tray
White round acrylic tray with matal handle
Silver retangle acrylic tray with handle
Custom black acrylic tray with artwork printing
Retangle acrylic tray with gold decoration
Custom transparent blue acrylic tray
Custom 6 sides clear acrylic tray
Custom judaica acrylic tray
Clear acrylic tray with metal handle